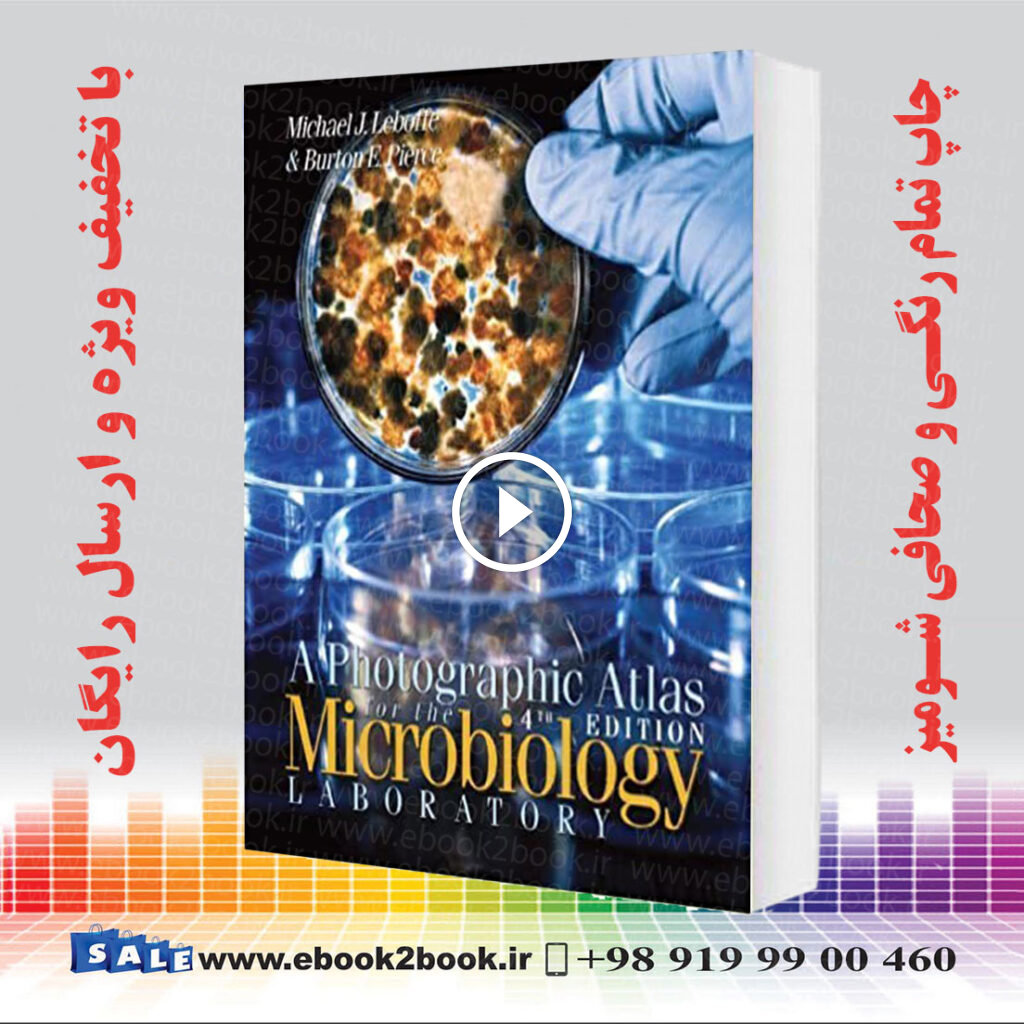
A Photographic Atlas for the Microbiology Laboratory 4th Edition

الی فایل
خرید و دانلود نسخه کامل کتاب Termodinámica e introducción a la mecánica estadística
گزارش
 الی فایل
الی فایل
خرید و دانلود نسخه کامل کتاب Termodinámica e introducción a la mecánica estadística
2ماه قبل
بررسی تغییرات قیمت
خرید و دانلود نسخه کامل کتاب Termodinámica e introducción a la mecánica estadística
محصولات مشابه

کتاب حفاظت سیستم های قدرت صنعتی

کتاب فرهنگ کشاورزی و منابع طبیعی جلدچهاردهم شیلات چاپ1385

خرید و دانلود نسخه کامل کتاب Concepts of particle physics

کتاب آنتی بیوتیک های بتالاکتام و مقاومت ها اثر شهین نجارپیرایه

خرید و دانلود نسخه کامل کتاب Graph Databases in Action
A Photographic Atlas for the Microbiology Laboratory 4th Edition

Lit : The Simple Protocol for Dental Photography

قیمت و خرید کتاب بیومکانیک و موتور کنترل حرکت انسان | ایده بوک

کتاب The Modern Vulkan Cookbook

خرید و دانلود نسخه کامل کتاب Classical dynamics. A contemporary approach

کتاب سفید 3

خرید و دانلود نسخه کامل کتاب Calculus Bible online

خرید و دانلود نسخه کامل کتاب Tata lectures on Theta III

خرید و دانلود نسخه کامل کتاب Targeted Radionuclide Tumor Therapy: Biological Aspects

Journal of the American Pharmacists Association Volume 61 Issu

خرید و دانلود نسخه کامل کتاب Data Analysis Methods in Physical Oceanography

کتاب معدن کاری زیر زمینی

خرید و دانلود نسخه کامل کتاب Python Standard Library: A Quickstudy Laminated Reference Guide

کتاب Simulation-Driven Electronics Design

ASP.NET Core 8 and Angular, 6th Edition
بازدید های اخیر

اداپتور 12 ولت 5 امپر
ناموجود
در باسلام

پرینتر لیزری تک کاره اچ پی استوک مدل HP LaserJet Pro M402n
ناموجود
در کامپیوتر پارسیان

میکروسکوپ دیجیتال دستی سلسترون مدل Deluxe Handheld
15,800,000 تومانء
در ایران کمپینگ

باتری لیتیوم یون مدل ICR-6671 ظرفیت 60 میلی آمپر ساعت
66,000 تومانء
در دیجی کالا

تحقیق اهمیت نان در اسلام
35,000 تومانء
در فارس فایل

بازی Uncharted Legacy Of Thieves Collection برای کنسول PS5
ناموجود
در آل موبایل

شکلات غلات رژیمی اوت چوکو Oat Choco بسته 400 گرمی
225,000 تومانء
در باسلام
Hello, world! This is a toast message.

